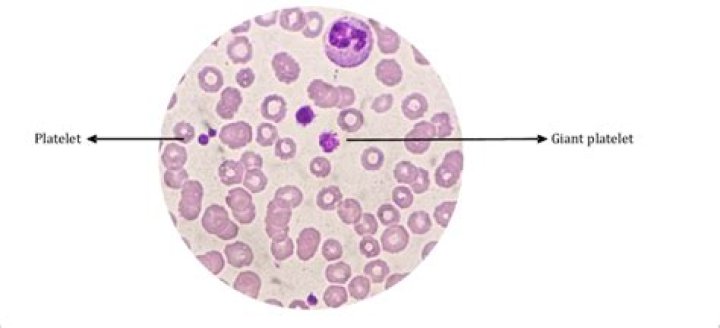

mantra, in Hinduism and Buddhism, a sacred utterance (syllable, word, or verse) that is considered to possess mystical or spiritual efficacy. Various mantras are either spoken aloud or merely sounded internally in one’s thoughts, and they are either repeated continuously for some time or just sounded once.
What is the most powerful Buddhist mantra?
Om mani padme hum. Oṃ maṇi padme hūṃ (Sanskrit: ॐ मणि पद्मे हूँ, IPA: [õːː mɐɳɪ pɐdmeː ɦũː]) is the six-syllabled Sanskrit mantra particularly associated with the four-armed Shadakshari form of Avalokiteshvara, the bodhisattva of compassion.
Which Buddhist mantra should I chant?
The most famous chant in the world is the Compassionate Buddha “Om Mani Padme Hum” which translates to “Hail to the jewel in the lotus.” It is the mantra of the Buddha of Compassion, known by the Chinese as Goddess Kuan Yin. The mantra calms fears, soothes concerns and heals broken hearts.
What are the three Buddhist mantras?
- Buddhabhivadana (Preliminary Reverence for the Buddha)
- Tisarana (The Three Refuges)
- Pancasila (The Five Precepts)
- Buddha Vandana (Salutation to the Buddha)
- Dhamma Vandana (Salutation to his Teaching)
- Sangha Vandana (Salutation to his Community of Noble Disciples)
What is the Buddhist chant called?
This chant is arguably the most famous chant in the whole world, even though it’s kind of unknown in the west. It’s called the Compassion of Buddha. It goes “Om Mani Padme Hum” which translates as “hail to the jewel in the lotus.”
What means Om Mani Padme Hum?
Takeaway: Om Mani Padme Hum is a well-loved Buddhist mantra commonly translated as, “The jewel is in the lotus.” … It is repeated over and over again to invoke the loving and unconditional qualities of compassion.
What are some Buddhist prayers?
- Being Peace. If we are peaceful, …
- With Every Breath. With every breath I take today, …
- Bodhisattva Prayer For Humanity* May I be a guard for those who need protection, …
- Offering The Mandala. Here is the great Earth, …
- Sky Is Free. …
- Prayer For Youth. …
- Giving To Those In Need. …
- Harmony.
What language is Nam Myoho Renge Kyo?
Myoho-renge-kyo is the title of the Lotus Sutra in Japanese. Nam comes from the Sanskrit namas, meaning to devote or dedicate oneself.What are Buddhist mudras?
mudra, Sanskrit Mudrā, (“seal,” “mark,” or “gesture”), in Buddhism and Hinduism, a symbolic gesture of the hands and fingers used either in ceremonies and dance or in sculpture and painting.
What is a good meditation mantra?- Aum or the Om. Pronounced ‘Ohm’. …
- Om Namah Shivaya. The translation is ‘I bow to Shiva’. …
- Hare Krishna. …
- I am that I am. …
- Aham-Prema. …
- Ho’oponopono. …
- Om Mani Padme Hum. …
- Buddho.
Which mantra should I chant before sleeping?
“Har Har Mukunde” is a belief that this mantra is helpful in calming the mind and bringing good sleep. It is said that chanting this mantra removes all the inner fears. And helps to get the mind out of mental obstacles. “Anga Sang Waheguru” by chanting this mantra gives relaxation to the mind and body.
What are some powerful mantras?
- Om Mani Padme Hum. This mantra comes from Buddhism and is related to the Bodhisattva of compassion. …
- Om Namah Shivaya. …
- Lokah Samastah Sukhino Bhavantu. …
- Tayata Om Bekanze. …
- Om Gum Ganapatayei Namah. …
- Om Vasudhare Svaha. …
- Gayatri mantra. …
- Ehi Vidhi Hoi Naath Hit Moraa.
What do monks chant?
Mahayana Buddhists recite a mantra called Nam Myoho Renge Kyo, which contains the concept that everyone has the ability to deal with and overcome any problems they encounter in their life. This concept means that, as humans, we have the ability to transform any suffering into non-suffering.
What is the difference between a chant and a mantra?
What Is Chanting? … Chanting may sound similar to repeating a mantra, but chanting your mantra brings a song-like, vibratory energy that can further connect your body and mind. The vibrations created from chanting also stimulate various chakras in the body.
Why do monks chant Om?
Om, symbolically embodies the divine energy, or Shakti, and its three main characteristics: creation, preservation, and liberation. … Om is the basic sound of the universe; chanting it symbolically and physically tunes us into that sound and acknowledges our connection to everything in the world and the Universe.
What do Buddhist say instead of amen?
As a syncretic Buddhist, I have never personally heard “haha”. You may be mistyping or mishearing “Svāhā (in Tibet: soha)” which is a common phrase in mantras, meaning “well said”. Although “amen” is a very strongly Christian word, it has somewhat of a correlation to svaha in that it tends to finish off “prayers”.
What do Buddhist say before they eat?
“Nam Myoho Renge Kyo” means “devotion to the Mystic Law of the Lotus Sutra,” which is the foundation of Nichiren practice. “Itadakimasu” means “I receive,” and is an expression of gratitude to everyone who had a hand in preparing the meal. In Japan, it is also used to mean something like “Let’s eat!”
Is Namaste a Buddhist greeting?
Namaste is a greeting in Indian languages. Not Buddhist.
Does Buddha believe in God?
Buddhists do not believe in any kind of deity or god, although there are supernatural figures who can help or hinder people on the path towards enlightenment. Siddhartha Gautama was an Indian prince in the fifth century B.C.E. … The Buddha taught about Four Noble Truths.
What does praise to the Jewel in the Lotus mean?
Known as the Compassion Mantra, or the Jewel in the Lotus, this is a powerful Buddhist prayer. This mantra is a tool to train the mind to achieve ultimate peace and enjoyment. The mind dictates our experience of happiness and sadness, so we must learn to control our mind.
What is the meaning of Om Tare Tuttare Ture Soha?
I prostrate to the Liberator, Mother of all the Victorious Ones. The Tara mantra is OM TARE TUTTARE TURE SOHA. means liberating from samsara. TARE shows that Mother Tara liberates living beings from samsara, from true suffering, or problems. TUTTARE, liberates you from the fears.
How many Buddhist mudras are there?
Mudra is used in the iconography of Hindu and Buddhist art of the Indian subcontinent and described in the scriptures, such as Nātyaśāstra, which lists 24 asaṁyuta (“separated”, meaning “one-hand”) and 13 saṁyuta (“joined”, meaning “two-hand”) mudras. Mudra positions are usually formed by both the hand and the fingers.
What is the female Buddha called?
Tara, Tibetan Sgrol-ma, Buddhist saviour-goddess with numerous forms, widely popular in Nepal, Tibet, and Mongolia. She is the feminine counterpart of the bodhisattva (“buddha-to-be”) Avalokiteshvara.
What does Buddha hold in his hands?
He is seated on an open lotus flower and also holds one in his hand – the lotus is the symbol of purity. He has one hand raised in a gesture of reassurance, literally meaning have no fear.
Does Nam Myoho Renge Kyo really work?
Originally Answered: Does chanting Nam Myoho Renge Kyo actually work? Yes. Millions of people with no prior knowledge or experience of Nam Myoho Renge Kyo or no previous incentive to practice have tried it and discovered that it works.
What are the ten worlds in Buddhism?
The worlds are, in ascending order of the degree of free will, compassion and happiness one feels, the worlds of: (1) hell, (2) hungry spirits, (3) animals, (4) asuras, (5) human beings (6) heavenly beings, (7) voice-hearers, (8) cause-awakened ones, (9) bodhisattvas, and (10) Buddhas.
How do I find my mantra?
Typically, the best way to find your mantra is to ask yourself what it is you need. Let the deficit guide you instead of being a weakness but don’t become too attached to one mantra you think is right. It’s important to try new mantras on and see how they fit.
How do I choose a mantra?
When it comes to choosing a mantra, always use and trust your intuition. If you don’t like the sound of something or it feels difficult for you to pronounce, then feel free to experiment and try out another mantra. There is so much wisdom and magic in each of us, and mantras can be so personal.
What is silent mantra meditation?
What is mantra meditation? The practice of mantra meditation utilizes the silent repetition of a word or phrase as the point of focus to help hone a more focused awareness. It aids in the slowing down of mental activity and thought. Mantra meditation is not meant to stop your thoughts altogether.
What language are Buddhist mantras written in?
A mantra (Sanskrit: मन्त्र, romanized: mantra, /ˈmʌntrə/; Pali: mantaṃ) or mantram is a sacred utterance, a numinous sound, a syllable, word or phonemes, or group of words in Sanskrit, Pali and other languages believed by practitioners to have religious, magical or spiritual powers.
Which mantra should I chant after waking up?
Soon as you wake up in the morning repeat ,” Om namonArAyaNAya” 108 times.